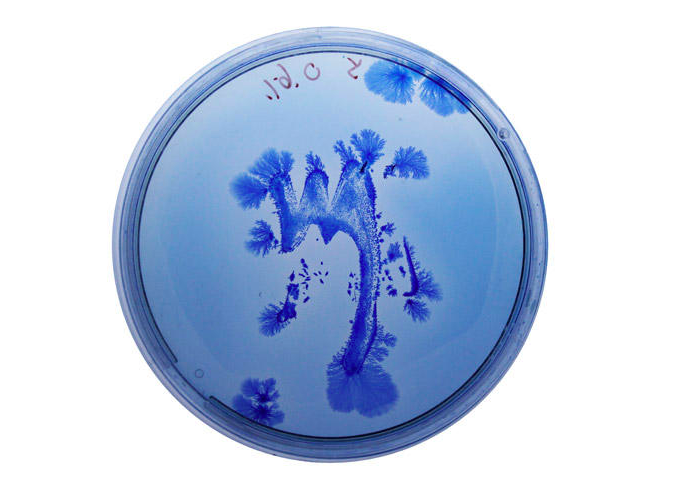
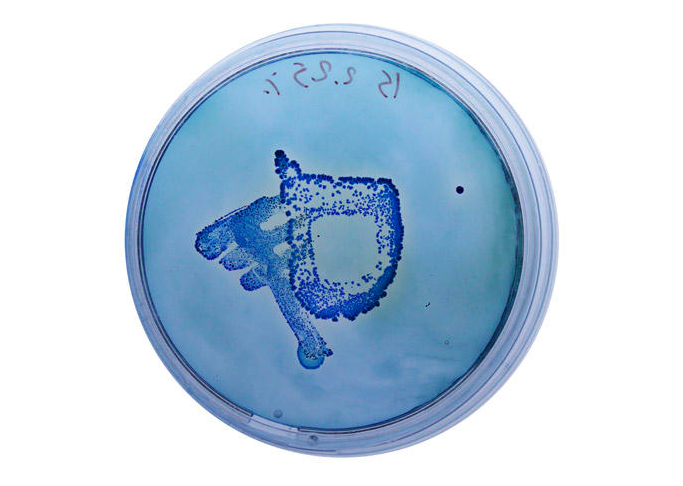
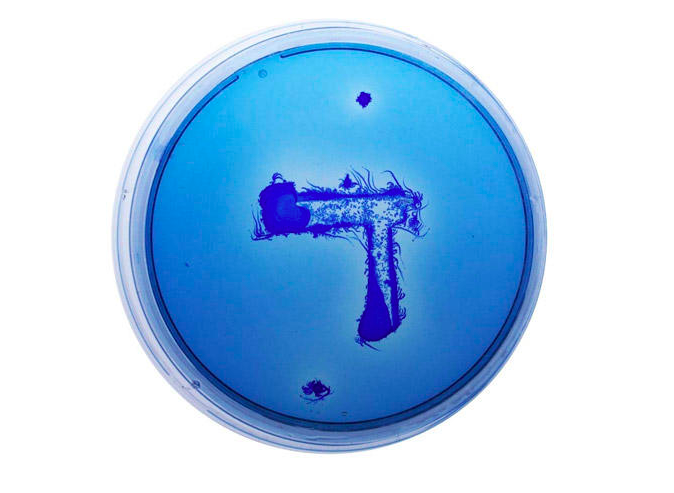
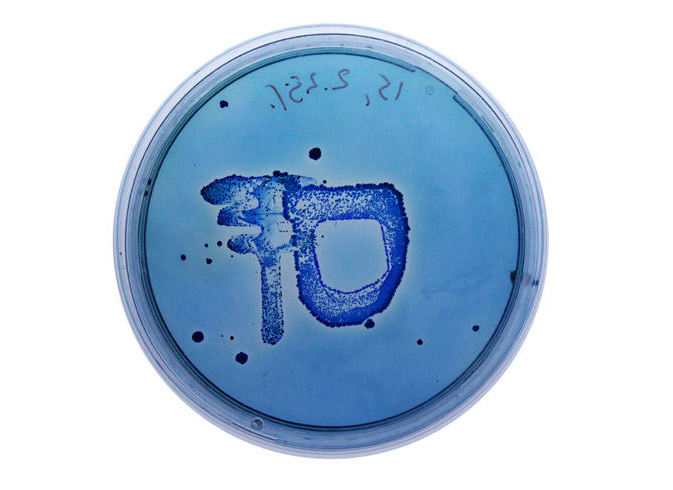
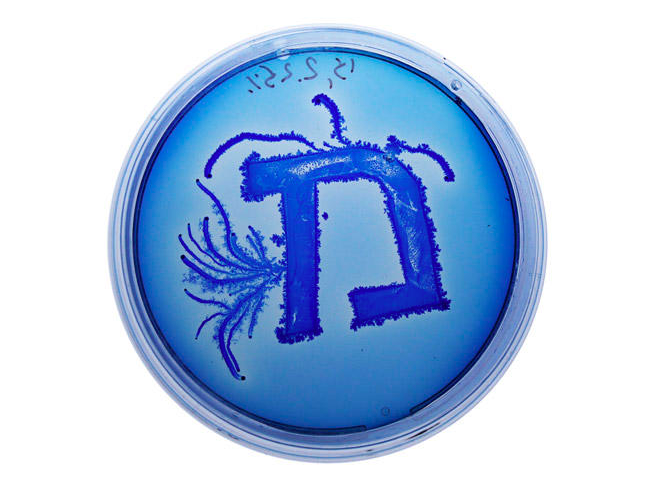

Ori Elisar, İsrail’deki Bezalel Sanat ve Tasarım Akademisi’ndeki final tezinin bir parçası olarak ilginç bir tipografi çalışması hazırlamış. Paenibacillus vortex bakterisini kullanan Elisar, bununla İbranice harflerden oluşan bir çalışma ortaya çıkarmış.
Tasarımcı; projesini, “Araştırmalarımı, yaptığım deneyleri ve elde ettiğim sonuçları kullanarak, doğayı, kültürü, karakter ve dili yeni teorilerle sorgulamayı umuyorum.” diye açıklıyor.
Fikir; ilk olarak 2 yıl önce, Tel Aviv Üniversitesi’nde profesör olan Eshel Ben-Jacob’ın yardımlarıyla ortaya çıkmış. Elisar, 3 ay boyunca zamanla gelişen biyolojik bir mürekkep geliştirme konsepti üzerinde çalışmış. Üstüne 2 ay da harfleri büyütmek için çalışmış. Elisar bu çalışmasıyla, İbrani alfabesinin gelişimine, dünyadaki yaşamın biyolojik evrimiyle ayna tutmak istemiş.
Elisar ilk olarak bakterileri, eski harflerin şeklinde bakteri üretme tabaklarına yerleştiriyor. İkinci aşamada ise modern harflerin formunda deniz yosunu proteini ekliyor. Artık iş bakterilere kalıyor ve zamanla harflerin formunu almaya başlıyorlar. Bakteriler, yavaşca deniz yosunu proteinini yemeğe başlıyor ve yeni harflerin formuna bürünüyor. Bu süreçte, bakteri üretme tabaklarının içinde dilin dönüşümüne tanık oluyoruz.

Görsel; dezeen






